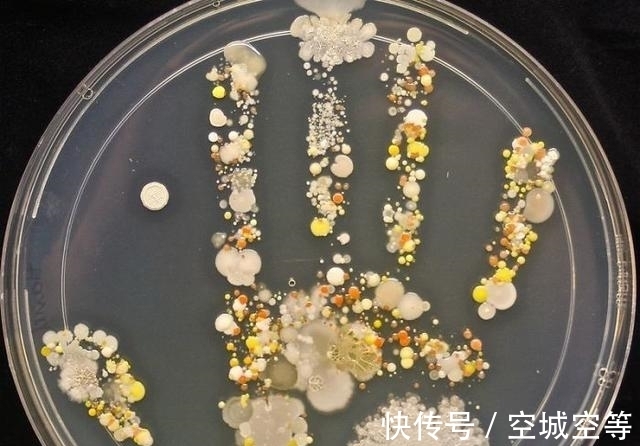
高尔夫球场#30张“活久未见”的照片:被闪电击中的木头,好像一副国画

高尔夫球场#30张“活久未见”的照片:被闪电击中的木头,好像一副国画
又到活久未见系列,今天的这组照片是一组罕见的自然照。有闪电击中高尔夫球场、沥青马路、沙子、树木后的样子,实在让人眼界大开。废话不多说了,直接上图吧!
在没有iPad这些电子产品前,玻璃球是每个男孩的必不可少的玩具,这个玻璃球是大理石烧热后,投入冷水后的效果。小编小时候也玩过,只不过那时候是玻璃球。

文章插图
闪电击中高尔夫球场,可以想到瞬间温度多高

文章插图
相信大家都吃过那种“快到碗里来的”的那种糖,任选3粒放到水中后就是这效果

文章插图
闪电击中木头,好像一幅国画,感叹大自然真是一个艺术家

文章插图
这是一个车轮,可以设想一下,开车地方的温度,滴水成冰

文章插图
密集恐惧症慎入,这是老外经常吃的甜菜

文章插图
吃剩的的菜,居然生出豆芽

文章插图
真是相亲相爱的一家人啊

文章插图
不解释看不出来这张照片的亮点,这是拍摄时,一个闪光灯刚要熄灭时的样子

文章插图
天气太热,但这不是重点,请问大家看了第一反应是什么?

文章插图
吃了不该吃点东西

文章插图
这真是冰箱啊

文章插图
水管破裂的后体育馆

文章插图
种感觉要发生点什么,科幻片看多了

文章插图
看样子距离湖边太近不是好事

文章插图
雾天的风力发电机,好像千军万马

文章插图
廉价的盆景

文章插图
这张照片不是ps上的,瀑布的周围冻结而成

文章插图
闪电击中了沙漠

文章插图
一个孩子的手印,经过细菌培养后看看
文章插图
废弃的船已经变成流动的陆地

文章插图
为什么飞机的螺旋桨拍出的照片是这样的

文章插图
好像一个微缩景观

- 迎新春@大足区人民医院:张灯结彩迎新春
- 水墨丹青栏目组!书画名家张明智:「文化强国推广计划」年度风采展
- 第十六回#祸出口出!贾元春省亲回去后为何失宠,根本原因坏在她的一张嘴上!
- 中国艺术$艺术鉴赏网:张筱玲谈“八大山人”画中的“拙对变”「专栏」
- 鸡毛信!他在《鸡毛信》中演张连长,《家》中饰高大老爷,老演员百年诞辰
- 张旭玮#00后大学生8年徽瓷技艺之路
- 出版!南开画院画家作品集《张柏林集》出版
- 笔墨&丹青凝素志 丘壑述沧桑——张柏林画集序
- 张无忌@金庸取了3个好名字,连自己也无法超越,堪称经典中的经典
- 天哲$曾翔等人“丑书”系照妖镜,照完中书协原主席张海新作,便知缺啥
